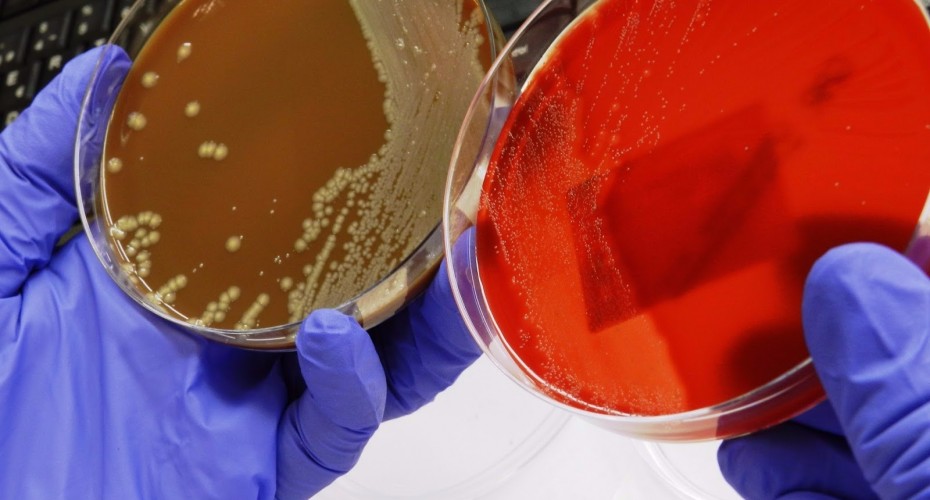
Lectura de cultius. Laboratori de Referència de Catalunya

Aquest programa de màster té com a objectiu principal proporcionar als llicenciats i graduats en ciències de la salut i ciències biomèdiques les competències en recerca clínica necessàries per a l'accés als estudis de doctorat.
La Microbiologia Clínica està experimentant un desenvolupament important, a causa de millores en les tècniques diagnòstiques tradicionals, a l'aplicació de mètodes de biologia molecular al diagnòstic i el control de les infeccions, i també per l'aparició i difusió de patògens emergents i/o *reemergentes. Aquest escenari trasllada a un primer nivell les possibilitats i aplicacions de la recerca en microbiologia.
Hi ha una demanda creixent d'alumnes provinents de llicenciatures i graus relacionats amb les ciències de la salut i la biologia humana que desitgen desenvolupar una carrera investigadora en aquest àmbit. Per això és necessari dominar diferents tècniques usades en la microbiologia clàssica i combinar-les amb tècniques moleculars, comunes a altres àmbits de la ciència.

D'altra banda, han d'interpretar-se correctament i en el context de cada microorganisme i de les infeccions que causa o en les quals participa. Aquest màster vol canalitzar l'interès per aquesta formació i oferir les eines metodològiques i un entorn favorable per al desenvolupament de tesis doctorals en diferents aspectes de la microbiologia. Entre uns altres, s'insisteix en la quimioteràpia bacteriana, tant en l'acció com en els mecanismes de virulència i de defensa que tenen els microorganismes, en l'epidemiologia clàssica i molecular i en el diagnòstic de les infeccions comunitàries i *nosocomiales. També es considera important el coneixement metodològic de les tècniques microbiològiques i de biologia molecular, així com l'estudi de les malalties infeccioses amb especificitats pròpies, com són la tuberculosi o les malalties parasitarias.
El principal objectiu és donar eines bàsiques, però sòlides per realitzar una tesi doctoral destacable en l'àmbit de la recerca dels microorganismes causants d'infeccions. Tenim la voluntat d'oferir un màster d'alta qualitat, amb continguts especialment dirigits a les àrees de coneixement en les quals els professors del màster són experts reconeguts. En el Màster de Microbiologia Clínica participen tres departaments de la Universitat de Barcelona i un de la Universitat Autònoma, així com els serveis o unitats de microbiologia dels hospitals Clinic, Sant Pau, Bellvitge, Vall d'Hebron, Parc Taulí, el Laboratori de Referència de Catalunya, els centres de recerca associats i també la Secció de Microbiologia de l'Hospital Sant Joan de Deu.
Els objectius concrets són ser la base per desenvolupar una tesi, proporcionar formació bàsica en aspectes rellevants de la recerca en Microbiologia Clínica, introduir als alumnes en la recerca a través de la realització d'un treball, fomentar l'esperit analític per desenvolupar habilitats en recerca biomèdica.